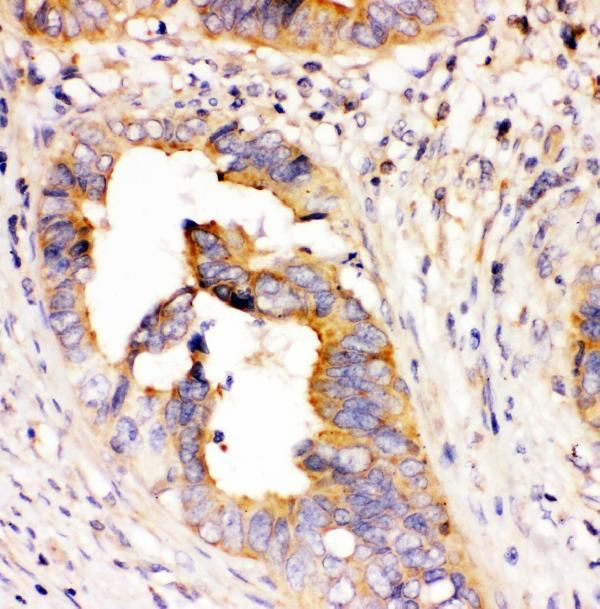
DHFR Antibody in Immunohistochemistry (Paraffin) (IHC (P))

Search
Invitrogen
DHFR Monoclonal Antibody (3C8)
{{$productOrderCtrl.translations['antibody.pdp.commerceCard.promotion.promotions']}}
{{$productOrderCtrl.translations['antibody.pdp.commerceCard.promotion.viewpromo']}}
{{$productOrderCtrl.translations['antibody.pdp.commerceCard.promotion.promocode']}}: {{promo.promoCode}} {{promo.promoTitle}} {{promo.promoDescription}}. {{$productOrderCtrl.translations['antibody.pdp.commerceCard.promotion.learnmore']}}
图: 1 / 3
DHFR Antibody (MA5-49170) in IHC (P)



Please note: We are reviewing Western blot images included in the antibody testing data in our catalog, including those provided by third parties. Unless expressly labeled or annotated as “raw-unedited”, Western blot images included in the antibody testing data in our catalog may have been edited, optimized or otherwise adjusted for presentation.
产品信息
MA5-49170
种属反应
宿主/亚型
分类
类型
克隆号
抗原
偶联物
形式
浓度
规格
纯化类型
保存液
内含物
保存条件
运输条件
RRID
产品详细信息
Adding 0.2 mL of distilled water will yield a concentration of 500 µg/mL.
Human DHFR shares 90% amino acid (aa)sequence identity with both mouse and rat DHFR.
Positive Control - WB: human K562 whole cell, human SGC-7901 whole cell, human Hela whole cell, human SW620 whole cell, rat kidney tissue. IHC: human rectal cancer tissue, rat gaster tissue.|Store at -20°C for one year from date of receipt. After reconstitution, at 4°C for one month. It can also be aliquotted and stored frozen at -20°C for six months. Avoid repeated freeze-thaw cycles.
靶标信息
Dihydrofolate reductase converts dihydrofolate into tetrahydrofolate, and is required for the synthesis of purines, thymidylic acid and certain amino acids. While the functional dihydrofolate reductase gene has been mapped to chromosome 5, multiple intronless processed pseudogenes or dihydrofolate reductase like genes have been identified on separate chromosomes. Dihydrofolate reductase deficiency has been linked to megaloblastic anemia.
仅用于科研。不用于诊断过程。未经明确授权不得转售。
篇参考文献 (0)
生物信息学
蛋白别名: Dihydrofolate reductase; Dihydrofolate reductase 1 (active)
基因别名: DHFR; Dhfr1
UniProt ID: (Rat) Q920D2
Entrez Gene ID: (Rat) 24312